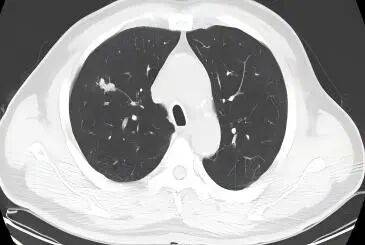
图片2.jpg

为生命加油丨从治疗困境到超3年长生存,一例广泛期小细胞肺癌伴骨转移患者的生命奇迹
小细胞肺癌(SCLC)侵袭性强、预后差,过去30多年来,传统治疗手段的局限性使广大患者的生存预后难以实现突破。近年来,免疫治疗的快速发展为ES-SCLC患者带来了长生存甚至临床治愈的新希望。在此背景下,《中国医学论坛报》联合中国临床肿瘤学会(CSCO)小细胞肺癌专委会,特别发起“为生命加油”小细胞肺癌长生存优秀病例展播项目,旨在通过征集并展示接受免疫治疗的ES-SCLC长生存案例,为临床医生提供宝贵的参考,推动ES-SCLC一线治疗策略的不断优化和完善,助力我国肺癌诊疗事业高质量发展。
本期,我们分享一例66岁诊断为ES-SCLC患者的诊疗历程,经一线免疫联合化疗、放疗方案以及后续免疫单药维持治疗至今已达3年,以持久且稳健的长生存获益验证了斯鲁利单抗对ES-SCLC患者的治疗优势。
回顾来时路,从绝望到超3年长生存,一位广泛期小细胞肺癌伴骨转移患者抗癌心声

医者视角:突破疗效,超乎预期,免疫治疗点亮广泛期小细胞肺癌临床治愈之光
病例介绍

患者信息
一般情况:男性,66岁。
初诊信息:2022年9月,患者因咳嗽咳痰1月至外院就诊,查胸部CT示:右肺上叶尖段斑片灶,纵隔内淋巴结肿大。彩超提示右侧颈后部低回声结节,行右侧颈部肿物穿刺病理活检提示:(右侧颈部Ⅳ区淋巴结)淋巴结转移性小细胞神经内分泌癌。行全身PET/CT提示:右上肺结节伴右颈部、右锁骨下及纵隔多发肿大淋巴结,考虑右上肺癌伴多发淋巴结转移,L3椎体局部骨质密度欠均匀,首先考虑肿瘤转移可能性大,右下肺炎性结节可能。为求进一步治疗拟收治入院。
体格检查:ECOG评分1分,神清,精神一般,心肺听诊无特殊。
既往史:既往有高血压、糖尿病、腹主动脉瘤支架植入术、慢阻肺等病史。
个人史及家族史:吸烟史40年,1-2包/天,饮酒史6年,无家族性遗传病史。

辅助检查
2022-9-20 肿瘤标志物胃泌素释放肽前体:327.52pg/ml,癌胚抗原定量:16.57ng/ml
2022-09-20 颈部+胸部CT增强示:右锁骨上下窝见多发肿大淋巴结影,较大者约22×21mm;右肺上叶前段实性结节,大小约为17×8mm ;纵隔内见肿大淋巴结影,大小约11×23mm。
2022-10-12 腰椎MRI示:L3椎体骨质异常伴L3水平椎管狭窄,考虑转移瘤。

影像学检查图像(基线)

诊断
右上肺小细胞癌广泛期伴右颈部、右锁骨下及纵隔多发淋巴结、L3椎体转移

一线治疗
2022-09-22至2023-02-22,行第1-6周期免疫联合化疗,具体用药为:1周期斯鲁利单抗联合依托泊苷和卡铂,后因化疗后骨髓抑制,2-6周期改斯鲁利单抗联合依托泊苷和顺铂治疗。
局部治疗:因腰痛,2022-10-17至2022-10-24行腰椎转移灶姑息放疗,放疗后腰痛症状缓解。
疗效评估:3周期后、6周期后分别行颈胸部CT,病灶较前明显缩小,肿瘤标志物显著降低,疗效评价:PR。

影像学检查图像(基线、3周期后、6周期后)
2023-3-17起,开始予斯鲁利单抗单药免疫维持治疗至今。
8周期后复查PET-CT提示:1.右肺小细胞肺癌复查,双肺见少许结节及斑点灶,代谢不高,请与旧片对比。2.颈部、纵隔、右锁骨上下区淋巴结,代谢不高。3.L3椎体代谢轻度增高,骨转移?
局部治疗:免疫维持期间,疗效评价维持PR,经多学科会诊,2023.5.9-5.29行右肺、纵隔及右侧颈部淋巴结姑息放疗。
局部治疗:免疫维持治疗20周期后,2024.4复查颅脑MRI提示右侧额叶异常强化结节(新见),考虑转移瘤,因考虑为颅内寡病灶进展,请放疗科会诊后行颅脑姑息放疗。

影像学检查图像(颅脑放疗前、放疗后)
颅脑放疗后,继续免疫维持治疗至今。
2025.8复查胸部+腹部CT、骨扫描、颅脑MRI,提示肿瘤无复发进展,肿瘤标志物正常,疗效评价维持PR。


肿瘤标志物变化
治疗期间安全性评估:患者有肾上腺皮质功能减退,予小剂量激素替代治疗后好转,未见其他免疫治疗相关不良反应。
随访:至末次随访时间2025-09-05,患者仍在斯鲁利单抗单药维持治疗中。
诊治体会

谢晓娟
医学硕士
厦门医学院附属第二医院肿瘤内科主治医师
厦门市预防医学会肿瘤预防与控制专业委员会委员
作为本例患者的主管医师,回顾其近三年的治疗历程,我深切体会到免疫治疗为ES-SCLC这类患者所带来的变革性影响。该患者初诊时已为广泛期,伴有多发淋巴结及骨转移,疾病负荷较重,既往这类患者生存预后较差。然而该患者在接受6周期斯鲁利单抗联合化疗的一线治疗、斯鲁利单抗单药维持治疗后,至今实现了突破性的3年长生存,疗效瞩目。
在一线免疫联合化疗的过程中,患者在3周期后即达到PR的疗效,肿瘤标志物显著下降,体现了斯鲁利单抗联合化疗一线治疗方案具有强效的抗肿瘤治疗效果,6周期后疗效评价维持PR,后续予单药免疫维持治疗至今已达3年,展现出斯鲁利单抗持久且稳健的肿瘤控制潜力。此外,在整个治疗过程中,多学科的治疗也起到非常重要的辅助。在整个治疗期间,患者经历了3次的局部放疗。第一次腰椎骨转移病灶的姑息放疗,减轻了患者的疼痛症状、提高了生活质量。第二次胸部及淋巴结病灶的局部放疗,增加了肿瘤的局部控制率。第三次脑转移病灶的调强放疗,达到了局部寡转移病灶的控制。多学科的综合治疗,使患者在长期随访过程中总体疗效评价仍维持PR,达到3年的长生存,远超预期。同时,该患者治疗过程中出现肾上腺皮质功能减退,予以对症处理后临床可控,且未见其他免疫治疗相关不良反应,整体安全性良好,较好地保障了患者免疫治疗的长期顺利进行。
该病例超3年长生存获益从真实世界的角度力证斯鲁利单抗这一创新型PD-1抑制剂对ES-SCLC患者具有显著疗效和长生存获益,极大提升了医患双方在面对ES-SCLC这类高度侵袭性肿瘤时的治疗信心。期待未来伴随着临床实践中的广泛应用,更多ES-SCLC患者能从斯鲁利单抗治疗中见到长生存甚至临床治愈的曙光。
专家点评

罗炳清
厦门医学院附属第二医院肿瘤内科科主任、主任医师
中国医药教育协会腹部肿瘤医学综合康复分会 常委
中国南方肿瘤临床研究协会肺癌专委会 委员
福建省抗癌协会肿瘤靶向治疗专委会 常委
福建省抗癌协会肿瘤内科专委会 委员
福建省抗癌协会癌症康复与姑息专委会 委员
福建省抗癌协会多原发和不明原发肿瘤专委会 委员
福建省海峡肿瘤防治科技交流协会精准医学专委会 委员
福建省海峡医药卫生交流协会临床肿瘤学诊疗分会 常务理事
福建省精准医学科技协会第二届理事会 理事
厦门市预防医学会肿瘤预防与控制专委会 副主委
厦门市中西医结合学会肿瘤学分会 常委
厦门市抗癌协会第四届理事会 常务理事
厦门市医学会肿瘤学分会 常委
厦门市医师协会肿瘤医师分会 委员
SCLC恶性程度极高,早期即易发生远处转移,约2/3患者初诊即为ES-SCLC[1]。其中骨转移发生率可达30%–40%[2],脑转移发生率约50%[3]。传统化疗虽能在数周内迅速缩瘤,却因血脑屏障阻隔及肿瘤异质性,对骨、脑病灶的长期控制力有限。因此,ES-SCLC治疗策略的优化选择和临床管理,一直是困扰肿瘤科医师的难题。
回顾本病例,患者为66岁男性,2022年9月确诊为ES-SCLC,伴右颈部、锁骨下、纵隔多发淋巴结转移及L3椎体骨转移,后续治疗过程合并脑转移,属于典型的高肿瘤负荷、难治型患者。近年来,免疫治疗为ES-SCLC患者实现生存突破,我国原研创新型PD-1抑制剂斯鲁利单抗ASTRUM-005研究中期数据于2022年ASCO重磅披露[4]。研究结果显示,斯鲁利单抗联合化疗组突破性地实现15.4个月中位总生存期(OS)获益,较安慰剂组(10.9个月)显著延长,显著降低死亡风险37%[风险比(HR)=0.63,95%CI:0.49~0.82,P<0.001]。凭借突破性长生存获益,斯鲁利单抗联合化疗一线治疗ES-SCLC已于2022年纳入了《CSCO小细胞肺癌诊疗指南》推荐[5],基于此,本病例选择斯鲁利单抗联合化疗一线治疗以及后续斯鲁利单抗免疫单药维持治疗,以期能为患者实现更长生存。
在治疗过程中,患者3周期后就快速实现了PR且在后续长期随访中持续PR,治疗全程中未见严重治疗相关不良反应。至末次随访,患者已达3年的高质量长生存,这对于既往预后极差的ES-SCLC而言无疑是兼具长期生存和生活质量的双重获益。
在该患者接受斯鲁利单抗治疗的3年来,ASTRUM-005研究亦不断更新生存随访数据。2025年ASCO大会中,ASTRUM-005研究中位随访42.4个月生存数据显示,斯鲁利单抗联合化疗中位OS长达15.8个月,4年OS率高达21.9%[6]。这意味着超过1/5的患者能在该一线治疗方案中实现4年生存跨越,并有望实现临床治愈。结合真实世界患者的长生存获益和更长随访时间下的高级别循证医学证据,斯鲁利单抗联合化疗正在不断夯实其在ES-SCLC一线治疗中的标准地位,并将为更多患者实现长生存的希望。
展望未来,我们期待小细胞肺癌领域能实现更多突破和变革,为患者带来更多个体化、精准化的治疗选择,进一步提升长期生存率和生活质量,最终实现将ES-SCLC转变为可长期管理的慢性疾病,真正实现“为生命加油”的使命。
参考文献
1.Oronsky B,et al. Neoplasia 2017; 19: 842–47.
2.刘倩等.中国癌症杂志.2021年第31卷第1期 .
3.Rittberg R,et al. Am J Clin Oncol. 2021 Dec 1;44(12):629-638.
4.2022 ASCO abstract 8505.
5.中国临床肿瘤学会指南工作委员会.中国临床肿瘤学会(CSCO)小细胞肺癌诊疗指南-2022
6.2025 ASCO,Poster Bd 214.
本文由罗炳清教授、谢晓娟医生审校
收藏
回复(1)参与评论
评论列表






